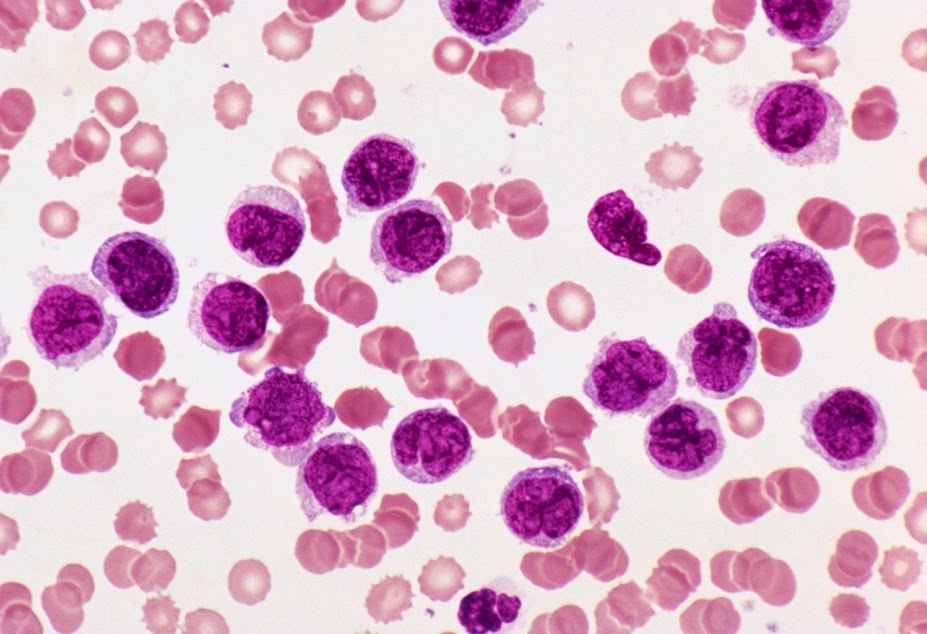

Leucemia Linfoblástica Aguda é o câncer das células brancas do sangue. A leucemia aguda significa que a doença progride rapidamente e de forma agressiva e requer tratamento imediato.A Leucemia Linfoblástica Aguda é classificada de acordo com o tipo de glóbulos brancos que são afetados pelo câncer.
Existem dois tipos principais:
- Linfócitos, que são principalmente usados para combater infecções virais
- Neutrófilos, que realizam diversas funções, tais como a luta contra infecções bacterianas, a defesa do organismo contra parasitas e prevenir a propagação do dano tecidual.
Sinais de aviso de Leucemia Linfoblástica Aguda
Os sintomas da leucemia Linfoblástica aguda geralmente começam lentamente antes de rapidamente ficando grave como o número de glóbulos brancos imaturos em seus sangue aumenta (veja abaixo para uma explicação sobre isso).
Os Principais sintomas incluem:
- Pele pálida
- Cansaço
- Falta de ar
- Ter infecções repetidas ao longo de um curto espaço de tempo
- Sangramento anormal e frequente.
O que acontece na Leucemia Linfoblástica Aguda
Todas as células do sangue no corpo são produzidas pela medula óssea. A medula óssea é um material esponjoso encontrado no interior dos ossos. É importante, porque produz células especiais denominadas células estaminais.
As células-tronco são muito úteis porque eles têm a capacidade de criar outras células especializadas que realizam funções importantes. As células-tronco na medula óssea produzir três tipos importantes de células sanguíneas:
- Glóbulos vermelhos, que transportam oxigénio pelo corpo
- Glóbulos brancos, que ajudam a combater as infecções
- Plaquetas, que ajudam a parar de sangrar.
Normalmente, a medula óssea produz células-tronco que são permitidos para amadurecer em células do sangue "adulto". No entanto, em casos de leucemia aguda, a medula óssea afectada começa a libertar um grande número de glóbulos brancos imaturos, que são conhecidos como células blásticas.
Os glóbulos brancos imaturos começa a romper-se rapidamente o equilíbrio normal das células no sangue. Isto significa que o corpo não tem glóbulos vermelhos suficientes ou células de plaquetas. Isto pode causar sintomas de anemia, tais como fadiga, e aumentam o risco de sangramento excessivo.
Além disso, como os glóbulos brancos não são devidamente formados tornam-se menos eficaz na luta contra bactérias e vírus, tornando-o mais vulnerável à infecção.
Se você tem leucemia aguda que não é tratada, você não será capaz de sobreviver porque seu suprimento de sangue não funcionará correctamente.
Quão comum é a Leucemia Linfoblástica Aguda?
A leucemia aguda é um tipo raro de câncer. Cerca de 7.600 pessoas são diagnosticadas com leucemia a cada ano no Reino Unido. Destes, apenas cerca de 650 pessoas têm leucemia linfoblástica aguda.
Apesar de incomum no geral, a leucemia linfoblástica aguda é o tipo mais comum de câncer a afectar as crianças. Cerca de 1 em cada 2.000 crianças irão desenvolvê-lo. Cerca de 85% dos casos ocorrem em crianças com idade inferior a 15 anos, com a maioria dos casos de desenvolvimento em pessoas entre as idades de dois e cinco anos de idade.
A causa ou causas da leucemia aguda são incertas, mas factores de risco conhecidos incluem:
- A exposição a altos níveis de radiação
- Exposição ao benzeno, um produto químico utilizado na fabricação de que também se encontra nos cigarros.
Perspectiva
As perspectivas para as crianças com leucemia Linfoblástica aguda é geralmente bom. Quase todas as crianças irão alcançar uma remissão (um período de tempo em que eles estão livres de sintomas) a partir de seus sintomas, e 85% será completamente curado.
As perspectivas para adultos com leucemia Linfoblástica aguda é menos promissor como apenas 40% das pessoas com a condição será completamente curado.
Os tratamentos para a leucemia Linfoblástica aguda geralmente envolvem uma combinação de quimioterapia e radioterapia. Em alguns casos, um transplante de medula óssea também possa ser necessária para alcançar a cura.
Se a cura não é possível, existe o risco de que a ausência de células de sangue saudáveis, pode tornar a pessoa extremamente vulnerável a infecções que ameaçam a vida (devido à falta de células brancas do sangue) ou descontrolada e hemorragias graves (devido à falta de plaquetas).
Sintomas Leucemia Linfoblástica Aguda
Os sintomas da leucemia linfoblástica aguda geralmente começam lentamente antes de rapidamente ficando grave como o número de células blásticas (glóbulos brancos imaturos) no seu sangue aumenta. A maioria dos sintomas é causada pela ausência de células de sangue saudáveis no seu abastecimento de sangue.
Os sintomas da leucemia linfoblástica aguda incluem:
- Pele pálida
- Cansaço
- Falta de ar
- Ter infecções repetidas ao longo de um curto espaço de tempo
- Hemorragias e frequentes, tais como sangramento nas gengivas ou hemorragias nasais
- Temperatura elevada (febre) de 38C (100.4F) ou acima
- Sudorese excessiva
- Óssea e dor nas articulações
- Pele facilmente machucado
- Inchaço dos gânglios linfáticos (glândulas)
- Fígado inchado
- Baço inchado
- Perda de peso.
Em alguns casos de leucemia linfoblástica aguda, as células afectadas podem se espalhar a partir de sua corrente sanguínea em seu sistema nervoso central. Isto pode causar uma série de sintomas neurológicos (relacionado com o cérebro e do sistema nervoso), incluindo:
- Dores de cabeça
- Convulsões (ataques)
- Vómitos
- Visão turva
- Tontura.
Ao procurar o conselho médico
Se você ou seu filho tem alguns ou mesmo todos os sintomas listados acima, ainda é muito pouco provável que a leucemia aguda é a causa.
No entanto, consulte o seu médico o mais rápido possível, porque qualquer condição que causa esses sintomas precisa ser prontamente investigadas e tratadas.
Causas Leucemia Linfoblástica Aguda
Leucemia linfoblástica aguda começa com uma alteração da estrutura do DNA encontrado nas células estaminais responsáveis pela produção de células brancas do sangue. Isso é conhecido como uma mutação genética.
O ADN fornece as células com um conjunto básico de instruções, como quando a crescer e se reproduzir. A mutação no ADN modifica essas instruções a fim de que as células-tronco produzir mais glóbulos brancos do que o necessário.
Os glóbulos brancos também são produzidos quando eles ainda são imaturos, para que eles não têm as propriedades que combatem a infecção de "adulto" glóbulos brancos saudáveis.
O número de células imaturas (blastos) aumenta rapidamente, conduzindo a uma diminuição correspondente dos glóbulos vermelhos e plaquetas. Esta redução de outros tipos de células do sangue faz com que muitos dos sintomas da leucemia aguda.
Não se sabe o que desencadeia o desenvolvimento da condição e faz com que a mutação inicial para ocorrer nas células estaminais. A maioria dos especialistas acredita que os desencadeantes de leucemia aguda diferem daquelas de leucemia aguda do adulto.
Possíveis desencadeadores da leucemia infantil
Pensa-se que cerca de 5% de infância casos de leucemia linfoblástica aguda são causadas por doenças genéticas relacionadas. Por exemplo, as taxas de leucemia tende a ser maior em crianças com síndrome de Down.
A exposição à radiação, seja antes ou depois do nascimento, é um conhecido factor de risco. No entanto, seria necessário um nível significativo de radiação, tais como a quantidade libertada durante o acidente do reactor nuclear em Chernobyl. Devido ao risco potencial de radiação para bebés em gestação, técnicas e equipamentos médicos que usam radiação, como raios-X, são raramente usados em mulheres grávidas.
A maioria dos casos de leucemia na infância ocorre em crianças sem histórico de doenças genéticas ou a exposição à radiação.
A teoria de "dois hit"
A maioria dos especialistas apoiar o que às vezes é referido como a teoria do "dois-hit" da leucemia infantil.
A teoria de "dois hit" afirma que um pequeno número de crianças nascem com uma vulnerabilidade pré-existente para o desenvolvimento de leucemia aguda, como uma mutação genética.
A teoria de "dois hit" afirma que um pequeno número de crianças nascem com uma vulnerabilidade pré-existente para o desenvolvimento de leucemia aguda, como uma mutação genética.
No entanto, a teoria sugere que eles vão manter-se saudável, a menos que eles são expostos a um segundo estímulo ambiental (hit), e é isto que é necessário para a condição de se desenvolver. Muitos pesquisadores acreditam que o segundo gatilho está ligada a uma infecção durante a infância.
O possível papel da infecção
Uma teoria afirma que as crianças que têm uma vulnerabilidade pré-existente para o desenvolvimento de leucemia aguda, e que não são expostos à infecção em idade precoce, pode desenvolver um sistema imunológico imaturo. Quando o sistema imune encontra finalmente uma infecção, de alguma forma, avarias e causa uma mutação nas células estaminais para ocorrer.
A evidência para apoiar esta teoria é que as crianças que frequentam infantários em tenra idade têm menos probabilidade de desenvolver leucemia aguda em comparação com aqueles que não frequentam grupos de jogos, quando eles são muito jovens.
As crianças que se misturam com os outros a partir de tenra idade estão expostas a infecções comuns da infância que activam e fortalecem o sistema imunológico, tornando-os mais resistentes a todas as infecções subsequentes.
Uma teoria alternativa é de que a leucemia pode ser o resultado de um aumento na mistura de diferentes populações. Por exemplo, quando as pessoas se deslocam a partir de diferentes partes do país e ir viver em uma nova cidade.
Isso pode expor as crianças com a vulnerabilidade pré-existente para o desenvolvimento de leucemia aguda a infecções que o seu sistema imunitário não aprendeu a reconhecer ou lidar com eles. Isto pode provocar um mau funcionamento semelhante e causar uma mutação nas células estaminais.
A prova disso é que grupos de casos de leucemia foram registrados perto de projectos de construção de grande escala, onde as famílias de todo o Reino Unido estão reunidas em um só lugar.
No entanto, estas teorias não estão sugerindo que a leucemia é infecciosa, mas que é causada por uma reacção rara a infecção.
Possíveis factores ambientais
Especialistas também realizaram uma extensa pesquisa, a fim de determinar se os seguintes factores ambientais pode ser um gatilho para a leucemia:
- Viver perto de uma estação de energia nuclear
- Viver perto de uma linha de energia
- Viver perto de um edifício ou instalação, que libera radiação electromagnética, como um mastro de telefonia móvel.
No momento não há nenhuma evidência para confirmar que qualquer um desses factores ambientais aumenta o risco de desenvolver leucemia.
Possíveis gatilhos para leucemia aguda em adultos
A exposição ao benzeno produto químico é um conhecido factor de risco para o adulto leucemia aguda. O benzeno é encontrado em gasolina e também é utilizada na indústria da borracha. No entanto, há controlos rígidos para proteger as pessoas da exposição prolongada.
O benzeno também é encontrado nos cigarros, o que poderia explicar por que os fumantes têm três vezes mais probabilidade de desenvolver leucemia aguda do que os não-fumantes. As pessoas que tiveram a quimioterapia e radioterapia para tratar mais cedo, cânceres não relacionados também têm um risco aumentado de desenvolvimento de leucemia aguda.
Tal como acontece com leucemia aguda, a exposição a níveis elevados de radiação é também um factor de risco. Pessoas que passam longos períodos de tempo em aviões também podem ser mais em risco por causa da alta altitude oferece menos protecção contra a radiação do sol. No entanto, o risco só é pensado para ser importante se você gastou pelo menos 5.000 horas de voo.
Diagnóstico Leucemia Linfoblástica Aguda
Quando pela primeira vez o diagnóstico de leucemia aguda, seu médico irá verificar se há sinais físicos da doença, tais como glândulas inchadas, e vamos providenciar para você ter exames de sangue.
Um número elevado de glóbulos brancos anormais na amostra de teste pode indicar a presença de leucemia aguda. Se o seu exame de sangue indica resultados anormais, você será encaminhado a um hematologista (especialista no tratamento de doenças do sangue).
A biópsia de medula óssea
Para confirmar o diagnóstico de leucemia aguda, o hematologista terá uma pequena amostra de sua medula óssea para examinar sob um microscópio. Este procedimento é conhecido como uma biopsia de medula óssea. A biópsia de medula óssea é usualmente levada a cabo sob uma anestesia local.
O hematologista vai paralisar uma área da pele na parte de trás de seu osso do quadril antes de usar uma agulha para retirar uma amostra de medula óssea. O procedimento é geralmente indolor, embora você pode experimentar alguns hematomas e desconforto por alguns dias depois. O procedimento leva cerca de 15 minutos para ser concluído e você não deve ter que ficar no hospital durante a noite.
A amostra de medula óssea será verificado para as células cancerosas. Se as células cancerosas estão presentes, o fragmento também será capaz de determinar qual o tipo de leucemia aguda está presente.
Outros testes
Existem vários testes adicionais que podem ser usados para ajudar a revelar mais informações sobre o progresso e a extensão da leucemia. Eles também podem fornecer uma visão de como a leucemia deve ser tratada. Estes testes são descritos abaixo.
Testes de citogenética
Testes de citogenética envolve identificar a composição genética das células cancerosas. Existem variações genéticas específicas que podem ocorrer durante a leucemia, e saber o que essas variações são pode ter um impacto importante sobre o tratamento.
Biópsia de linfonodo
Se você foi diagnosticado com leucemia aguda, mais biópsias podem ser realizadas em qualquer aumento dos gânglios linfáticos que você tem. Estes serão capazes de determinar até que ponto a leucemia se espalhou.
Tomografias computadorizadas
Se você tem leucemia aguda, uma tomografia computadorizada pode ser usado para verificar se os seus órgãos, como o coração e os pulmões, são saudáveis.
A punção lombar
Se se considerar que existe um risco de que a leucemia aguda se espalhou para o sistema nervoso, uma punção lombar pode ser levada a cabo.
A punção lombar é um teste em que uma agulha é usada para extrair uma amostra de líquido cefalorraquidiano (líquido que envolve e protege a coluna vertebral) a partir de suas costas. O fluido é testado para determinar se a leucemia atingiu seu sistema nervoso.
Tratamento Leucemia Linfoblástica Aguda
A equipe de tratamento, muitas vezes, inclui:
- Um hemato-oncologista (especialista no tratamento não-cirúrgico de leucemia usando técnicas como a quimioterapia)
- Um hemato-patologista (especialista no estudo de células sanguíneas cancerosas)
- Um pediatra (um médico especializado no tratamento de crianças)
- Um farmacêutico
- Um assistente social
- Um psicólogo
- Uma enfermeira especialista em câncer (que servirá como o primeiro ponto de contato entre você e os membros da equipa de cuidados).
Ensaios clínicos
No Reino Unido, os ensaios clínicos estão em andamento que visam encontrar a melhor maneira de tratar a leucemia aguda. Os ensaios clínicos são estudos que utilizam técnicas novas e experimentais para ver quão bem eles trabalham no tratamento e, possivelmente, a cura de leucemia aguda.
É importante estar ciente de que não há garantia de que as técnicas que estão sendo estudadas no ensaio clínico será mais eficaz do que os tratamentos atuais.
Sua equipe de atendimento será capaz de deixá-lo saber se existem ensaios clínicos disponíveis em sua área, e pode explicar os benefícios e os riscos envolvidos.
Tal como leucemia aguda é uma condição que se desenvolve rapidamente agressivo, o tratamento geralmente começa alguns dias após o diagnóstico ter sido feito.
Devido à natureza muitas vezes complexa de leucemia aguda, a condição é normalmente tratada por uma equipe de especialistas diferentes trabalhando juntos. Esse tipo de equipa é conhecida como uma equipe multidisciplinar.
Etapas do tratamento
O tratamento para a leucemia linfoblástica aguda é realizada em etapas:
- Indução - o objetivo da fase inicial do tratamento é para matar as células de leucemia em sua medula óssea, restaurar o seu sangue para bom funcionamento e resolver quaisquer sintomas que você pode ter.
- Consolidação - este estágio tem como objetivo matar todas as células de leucemia restantes que podem estar presentes em seu sistema nervoso central.
- Manutenção - a fase final envolve tomar doses regulares de comprimidos de quimioterapia para evitar que a leucemia de retornar.
Manutenção apenas parece ser eficaz no tratamento da leucemia linfoblástica aguda; que não é normalmente usada no tratamento de leucemia mielóide aguda.
Indução
A fase de indução de tratamento é realizada no hospital ou em um centro especializado. Isso é porque você provavelmente precisará ter transfusões de sangue regulares, pois é provável que seu sangue não contém células sanguíneas saudáveis o suficiente.
Você também será vulnerável à infecção, por isso é importante que você esteja em um ambiente estéril, onde a sua saúde pode ser cuidadosamente monitorizados e qualquer infecção que você pode ser tratado prontamente. Vocês também podem ser prescritos antibióticos para ajudar a prevenir novas infecções.
Quimioterapia
Você será dado uma combinação de quimioterapia medicação para matar as células de leucemia na sua medula óssea. À medida que você vai precisar ter muitos medicamentos como parte do seu tratamento, um tubo será inserido em uma grande veia perto do seu coração. Isso é conhecido como uma linha central. Ter uma linha central significa que você não vai precisar ter muitas injecções dolorosas.
Algum medicamento de quimioterapia também pode ser administrado directamente em seu líquido cefalorraquidiano para matar todas as células de leucemia que podem ter se espalhado no seu sistema nervoso. Esta é administrada usando uma agulha que é colocada na sua coluna, de uma maneira semelhante a um punção lombar.
Os efeitos secundários que ocorrem quimioterapia seguinte são comuns. Eles podem incluir:
- Náusea
- Vómitos
- Diarreia
- Perda de apetite
- Úlceras na boca
- Cansaço
- Erupções cutâneas
- Infertilidade
- Perda de cabelo.
Os efeitos colaterais devem resolver quando o tratamento terminou. Seu cabelo normalmente irá levar entre três a seis meses para voltar a crescer.
Imatinib
Se você tem o tipo conhecido como cromossomo Philadelphia leucemia linfoblástica aguda positiva, você também será dado um medicamento chamado imatinib. Imatinib funciona bloqueando os sinais nas células cancerosas que os fazem crescer e reproduzir-se. Isto mata as células cancerosas.
Imatinib é feita por via oral (como um comprimido). Os efeitos colaterais do imatinib são geralmente leves e deve melhorar com o tempo. Eles incluem:
- Náusea
- Vómitos
- Inchaço no rosto e pernas
- Cãibras musculares
- Erupção
- Diarreia.
Dependendo da forma como você responder ao tratamento, a fase de indução pode durar de duas semanas a vários meses. Em alguns casos, você ou seu filho pode ser capaz de deixar o hospital e receber tratamento em regime de ambulatório se os sintomas melhoram.
Consolidação
Leucemia pode voltar se apenas uma célula cancerosa permanece em seu corpo. Por conseguinte, o objectivo do tratamento de consolidação é de assegurar que todas as células de leucemia remanescentes são mortas.
O tratamento envolve a receber injecções regulares de medicamentos de quimioterapia. Isso geralmente é feito em nível ambulatorial, o que significa que você não terá que ficar no hospital durante a noite. No entanto, você pode necessitar de alguns curtas estadias no hospital se os seus sintomas se agravarem ou de repente se você desenvolver uma infecção. A fase de consolidação do tratamento dura vários meses.
Manutenção
A fase de manutenção é concebido para funcionar como mais seguro contra a possibilidade de a leucemia voltar. Trata-se de tomar doses regulares de comprimidos de quimioterapia ao se submeter a check-ups regulares para monitorar a eficácia de seu tratamento está a revelar. A fase de manutenção, muitas vezes pode durar dois anos.
Outros tratamentos
Assim como quimioterapia e imatinib, outros tratamentos são usados em algumas circunstâncias. Estes encontram-se descritos abaixo.
Dasatinib
O dasatinib é um novo tipo de medicamento usado para tratar a leucemia linfoblástica aguda Filadélfia cromossomo positivo, quando todos os outros tratamentos não têm obtido sucesso.
Dasatinib é um inibidor da tirosina quinase. Isto significa que os blocos de uma proteína chamada tirosina quinase que ajudam a estimular o crescimento de células cancerosas.
Dasatinib não pode curar leucemia aguda, mas pode retardar o seu crescimento, ajudando a aliviar os sintomas e prolongar a vida útil.
O Instituto Nacional de Saúde e Excelência Clínica (NICE) ainda não tomou uma decisão sobre se o SNS deve fornecer tratamento com dasatinib para pessoas com leucemia aguda. Isso significa que ele vai ficar a critério de sua confiança cuidados primários locais para saber se você será oferecido a droga.
Radioterapia
A radioterapia envolve o uso de altas doses de radiação controlada para matar as células cancerosas. Há duas razões principais pelas quais a radioterapia é geralmente usado para tratar leucemia aguda:
- Às vezes tratar casos avançados de leucemia linfoblástica aguda que se espalharam para o sistema nervoso ou cérebro
- Para preparar o corpo para um transplante de medula óssea (veja abaixo).
Os efeitos colaterais dos dois tipos de radioterapia incluem:
- Perda de cabelo
- Náusea
- Fadiga.
Os efeitos colaterais devem passar uma vez que seu curso de radioterapia foi concluído. No entanto, a pele pode ser muito sensíveis aos efeitos da luz durante vários meses após o tratamento ter terminado. Se este for o caso, evitar banhos de sol ou exposição a fontes de luz artificial, como por exemplo solários, durante vários meses.
Muitas crianças mais jovens tratados com radioterapia vão continuar a ter limitado o crescimento físico durante a puberdade.
Um pequeno número de pessoas desenvolve catarata vários anos após a radioterapia. As cataratas são manchas nublado durante a lente (a estrutura transparente na frente do olho) que pode tornar a sua visão turva ou enevoada. A catarata geralmente pode ser tratada com sucesso com a cirurgia.
Transplantes de medula óssea e de células-tronco
Se você ou seu filho não respondem à quimioterapia, uma possível opção de tratamento alternativa é medula óssea ou transplante de células estaminais.
Antes do transplante pode ter lugar, a pessoa que recebe o transplante precisará ter altas doses de quimioterapia agressiva e radioterapia para destruir quaisquer células cancerígenas em seu corpo. Isso pode colocar uma enorme pressão sobre o corpo e causar efeitos colaterais significativos e potenciais complicações.
Transplantes têm melhores resultados se o doador tem o mesmo tipo de tecido como a pessoa que está recebendo a doação. O melhor candidato para fornecer uma doação é geralmente um irmão ou irmã com o mesmo tipo de tecido.
Devido a esses problemas, os transplantes são geralmente só sucesso quando eles são realizados em crianças e jovens, ou pessoas idosas que estão em boa saúde, e quando não há um doador adequado, tal como um irmão ou irmã.
Complicações Leucemia Linfoblástica Aguda
Ter um sistema imunológico enfraquecido é uma complicação comum de leucemia aguda. O termo médico para ter um sistema imunológico enfraquecido está sendo " imunodeprimidos ".
Mesmo que o seu sangue é restaurado para a ordem normal de trabalho, muitos dos medicamentos que são usados no tratamento da leucemia aguda têm o efeito colateral de enfraquecer o sistema imunológico.
Isto significa que você está mais vulnerável ao desenvolvimento de uma infecção, e que qualquer infecção que você tem um maior potencial de causar sérias complicações. Você pode ser aconselhado a tomar doses regulares de antibióticos para evitar infecções.
Evite o contacto com qualquer um que é conhecido por ter uma infecção, mesmo que seja um tipo de infecção que você estava anteriormente imune a, como catapora ou sarampo. Isto porque a sua imunidade anterior a essas condições podem ser suprimidos.
Embora seja importante que ir para fora em uma base regular, tanto para o exercício e para o seu bem-estar psicológico, evite visitar lugares aglomerados e usar o transporte público durante a hora do rush.
Assinalar eventuais sintomas de uma infecção imediatamente ao seu médico de família ou equipe cuidado porque o tratamento imediato pode ser necessário para evitar complicações graves.
Os sintomas da infecção incluem:
- Temperatura elevada (febre) de 38C (100.4F) ou acima
- Dor de cabeça
- Dores musculares
- Diarreia
- Cansaço.
Também garantir que todas as suas vacinas estão up-to-date. O seu médico será capaz de aconselhá-lo sobre isso.
No entanto, você não será capaz de ter qualquer vacina que contém partículas activadas de vírus de bactérias, tais como:
- Caxumba, sarampo e vacina (MMR) rubéola
- A vacina contra a poliomielite
- A vacina contra o tifo bucal
- A vacina BCG (usada para vacinar contra a tuberculose)
- A vacina contra a febre-amarela.
Hemorragia
Se você tem leucemia aguda, você vai sangrar e nódoas negras mais facilmente, devido aos baixos níveis de plaquetas (células formadoras de coágulo) em seu sangue. O sangramento pode também ser excessivo quando ela ocorrer.
O sangramento pode ocorrer:
- No interior do crânio (hemorragia intracraniana)
- Dentro dos pulmões (hemorragia pulmonar)
- No interior do estômago (hemorragia gastrointestinal).
Os sintomas de uma hemorragia intracraniana incluem:
- Forte dor de cabeça
- Torcicolo
- Vómitos
- Alteração do estado mental, tais como confusão.
Os sintomas mais comuns de uma hemorragia pulmonar são:
- Tosse com sangue de seu nariz e boca
- Dificuldades respiratórias
- Um tom de pele azulada (cianose).
Os dois sintomas mais comuns de uma hemorragia gastrointestinal são:
- Vomitar sangue
- Fezes escuras.
Infertilidade
Muitos dos tratamentos que são utilizados para o tratamento de leucemia aguda pode causar infertilidade. Infertilidade é muitas vezes temporária, embora em alguns casos, pode ser permanente.
As pessoas que estão particularmente em risco de se tornarem inférteis são aqueles que receberam altas doses de quimioterapia e radioterapia em preparação para a medula óssea ou transplante de células estaminais.
Sua equipe multidisciplinar será capaz de lhe fornecer uma boa estimativa sobre o risco de infertilidade em suas circunstâncias específicas.
Pode ser possível para evitar qualquer risco de infertilidade antes de começar o seu tratamento. Por exemplo, os homens podem ter amostras de seu esperma armazenado. Da mesma forma, as mulheres podem ter embriões fertilizados armazenadas, o qual pode então ser colocada de volta para o seu útero a seguir ao tratamento.
http://www.nhs.uk/Conditions/Scurvy/Pages/Introduction.aspx